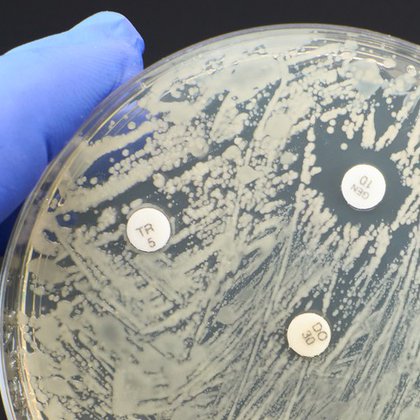
Tweet card summary image

Chris Barden
@ChrisB_Biotech
Followers
69
Following
802
Media
22
Statuses
223
Life sciences entrepreneur, computational scientist, and patent agent. @[email protected] Rom 8:18
Toronto, Ontario
Joined November 2018
These are the small companies and research groups @CARB_X supports at global scale. Not one or two, but dozens at a time. They need both money and scientific, business, and technical help turning ideas into products
Do you know who is leading AMR research today? ▶ 93% of clinical R&D is lead by small companies ▶ 86.7% of preclinical R&D too! Small companies and biotech are at the forefront of antibacterial development. 👉 Read more here https://t.co/kKibRGMUT7
1
7
20
Here is the Treventis #AAIC24 contingent! Drop us a line if you're in Philadelphia this week and would like to meet.
0
1
1
Good morning, #AAIC24 attendees! Are you ready to kick off an exciting week of sharing new ideas and discoveries? Scientific sessions start soon. Get today’s schedule at https://t.co/jdq5rM0vbg.
2
17
93
The pharma industry invents medicines that ease suffering & save lives. So why are we so bad at communicating the value being generated? From @PeterKolchinsky
rapport.racap.com
Many people who dedicate their lives to discovering, developing, and making new, lifesaving drugs don’t understand the extent to which the drug industry has failed to communicate its value proposit...
1
2
17
What's now for the Amyloid Hypothesis in #Alzheimers? Several recent studies using monoclonal antibodies show evidence that removing aggregated Aβ from the brains of symptomatic patients can slow the disease progression. Yes, despite the clinical benefit of these trials still
16
75
412
To say antimicrobial resistance (AMR) is a problem is an understatement. If nothing changes, by 2050, 10 million AMR-related deaths are expected to occur every year. Explore our resource page to learn about AMR, & how we can combat it. https://t.co/tcYObiQPww
#WAAW #USAAW23
asm.org
ASM is a nonprofit professional society that publishes scientific journals and advances microbiology through advocacy, global health and diversity in STEM programs.
2
91
174
Capping off a successful #BIOEUROPE by uncapping some traditional Bavarian fare! A great conference all around, thanks to all who met up while I was in Munich to speak about @Treventis_corp
0
0
2
Enjoying the capacious and efficient partnering layout this morning at #BIOEUROPE ... Drop me a DM if you'd like to meet and discuss protein #misfolding @Treventis_corp
0
0
2
So much can be learned from the Christchurch mutation, not only about potential new treatments but also the pathophysiology of AD broadly. Lots of plaques with few tangles and delayed clinical manifestations.
2
2
11
📣 I’m thrilled that 🇨🇦 will be joining Wellcome 🇺🇸🇩🇪🇬🇧and @gatesfoundation providing funds to @CARB_X. International partnership to coordinate investment in product development is key to saving lives from #AMR.
Government of Canada makes important investment to fight antimicrobial resistance (AMR) https://t.co/tg6x0a4NYi
0
6
26
Exciting news to share from Treventis!
prnewswire.com
/PRNewswire/ -- Treventis Corporation, a privately held biotechnology company, announced today that it has entered an option, collaboration, and license...
0
1
2
.@aliciadubinski from the @cvandevelde75 reports that stress granule assembly in vivo is deficient in the CNS of mutant TDP-43 ALS mice. https://t.co/gQVdOQzkgG
0
2
8
This is a great step forward for innovative payment models in antimicrobial development. Important that Japan is making this a priority.
The Japanese government is moving forward with their pull incentive, called the "Antimicrobial Securement Project" [抗菌薬確保支援事業]. This is a revenue guarantee pull incentive, akin to Sweden, but higher in funding amount.
0
0
1
Wheelock et al. provide new evidence that low cost and minimally invasive measurements of serum neurofilament light are a useful marker of functional connectivity and cognitive decline in Alzheimer’s disease. https://t.co/vXA4lQiJug
1
24
105
No amount of AD pathology is “normal” per se, but pretty much everyone develops NFTs in their lifetime. Ever wonder what amount of Alzheimer-type pathology is “normal”-ish at any given age? https://t.co/PhU3GNvuuF
#neuropath #alzheimers #neurology
pubmed.ncbi.nlm.nih.gov
These findings suggest that an increasing burden of neuritic plaques is a strong predictor of cognitive decline, whereas, neurofibrillary degeneration and amyloid-β (diffuse) plaque deposition, both...
6
26
95